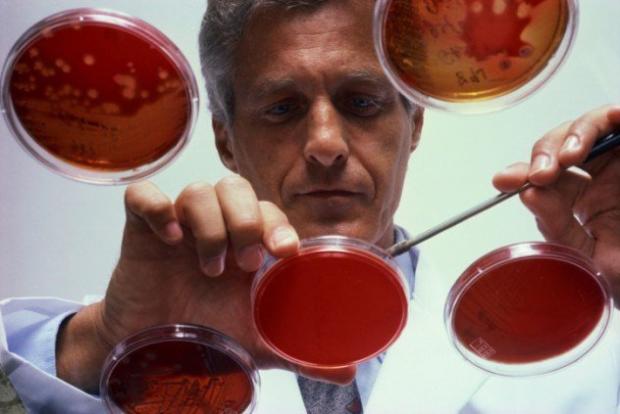

Bên cạnh những vi khuẩn có hại như vi khuẩn gây bệnh thương hàn, tiêu chảy,... thì có những loại vi khuẩn có lợi, giúp bảo vệ con người.
Lợi khuẩn probiotic. Probiotic là loại vi khuẩn có lợi giúp tăng cường sức khỏe hệ tiêu hóa. Đây là những vi sinh vật sống có lợi tự nhiên được tìm thấy trong ruột. Khi vào trong ruột, nó phá vỡ các thực phẩm mà chúng ta ăn vào để cung cấp một nguồn năng lượng cho các tế bào trong ruột, từ đó tăng cường hệ thống miễn dịch và giúp ngăn ngừa nhiễm trùng.
Vi khuẩn T-103. Vi khuẩn T-103 giúp chuyển hóa giấy thành nhiên liệu đốt. Loại vi khuẩn này được tìm thấy trong chất thải động vật, có thể sản xuất nhiên liệu sinh học butanol bằng cách ăn giấy. TU-103 cũng là chủng vi khuẩn kỵ khí duy nhất có thể sinh trưởng trong môi trường có oxy mà con người từng biết.
Vi khuẩn Clostridium Sporogenes. Vi khuẩn Clostridium Sporogenes có thể được sử dụng để tạo ra các loại thuốc trong điều trị ung thư nhờ vào khả năng tác động đến các khối u mục tiêu. Khi tiêm vi khuẩn này vào khối u, các vi khuẩn có thể giúp tiêu diệt các tế bào khối u mà không ảnh hưởng đến các mô khỏe mạnh.

Vi khuẩn Geobacter. Vi khuẩn Geobacter được sử dụng để giữ ổn định, ngăn chặn các chất độc hại như uranium phát triển rộng, hạn chế những hậu quả tai hại do các sự cố rò rỉ phóng xạ gây ra. Loại vi khuẩn này có cơ chế trao đổi chất đặc biệt là chuyển các electron cho kim loại để lấy năng lượng từ thức ăn. Trong quá trình chuyển electron, vi khuẩn Geobacter biến kim loại từ dạng hòa tan thành dạng rắn, làm cho kim loại tách khỏi nước ngầm. Vì vậy đây là loại vi khuẩn giúp tiêu thụ ô nhiễm phóng xạ khá hiệu quả.

Vi khuẩn Staphlococcus epiderrmis. Vi khuẩn Staphlococcus epiderrmis được xem là một phần không thể tách rời của cơ thể con người, có nhiệm vụ tấn công lại ký sinh trùng Leishmania major, thủ phạm gây bệnh nhiệt đen. Đây là loại vi khuẩn giúp bảo vệ da có lợi tồn tại ngay từ những phút đầu tiên khi chúng ta sinh ra.
Vi khuẩn Prokaryote. Vi khuẩn Prokaryote tồn tại trong đường tiêu hóa và trên bề mặt da. Loại vi khuẩn này kết hợp với các tế bào miễn dịch ở da bảo vệ cơ thể con người chống lại vi khuẩn gây bệnh và nấm xâm nhập cơ thể. Đây được xem là vi khuẩn có lợi và 'thân thiện' với con người.
Cập nhật: 08/11/2016
Theo kienthuc